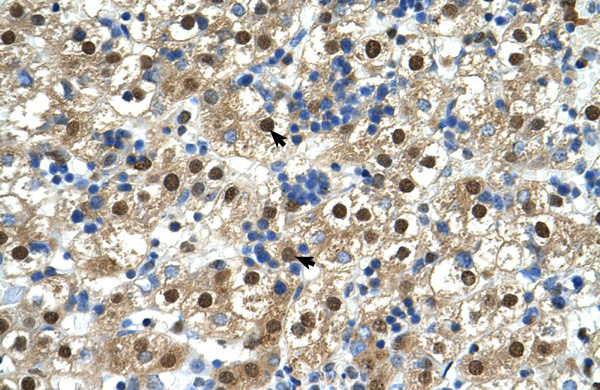
Antibody used in IHC on Human Liver. Antibody used in IHC on Human Liver.

GDE1 Antibody
Product Code:
PSI-30-276
PSI-30-276
Host Type:
Rabbit
Rabbit
Antibody Clonality:
Polyclonal
Polyclonal
Regulatory Status:
RUO
RUO
Target Species:
- Canine (dog)
- Human
- Mouse
- Rat
Applications:
- Enzyme-Linked Immunosorbent Assay (ELISA)
- Immunohistochemistry (IHC)
- Western Blot (WB)
Storage:
For short periods of storage (days) store at 4˚C. For longer periods of storage, store GDE1 antibody at -20˚C. As with any antibody avoid repeat freeze-thaw cycles.
For short periods of storage (days) store at 4˚C. For longer periods of storage, store GDE1 antibody at -20˚C. As with any antibody avoid repeat freeze-thaw cycles.
No additional charges, what you see is what you pay! *
| Code | Size | Price |
|---|
| PSI-30-276-100ul | 100ul | £662.00 |
Prices exclude any Taxes / VAT